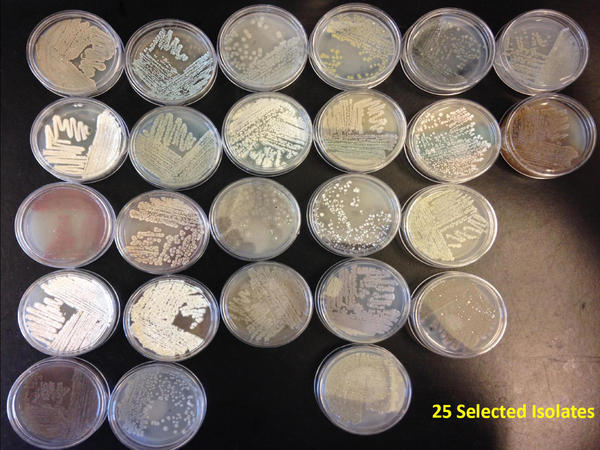

Current Projects
 |
The impact of natural products on modern society is indisputable given their importance to medicine. As one example, 42% of anticancer and 47% of anti-infective agents introduced over the past 25 years are natural products. While remarkable discoveries have been made, the rate of natural product discovery has declined in recent years, profoundly affecting the development of new therapeutics and the related pharmaceutical and biotechnology industries. The general aim of many projects in our lab is to conduct research in natural products chemistry and associated microbiology and genetics to develop innovative methods to improve natural product discovery from microbes of marine origin. |
Pseudopterosins

Microbial Diversity
|
Microbes (bacteria and fungi) are the source of all our natural products investigations and are obtained from a wide diversity of marine habitats. The marine environment represents an underexplored resource for microbial natural product discovery thus improving the likelihood of isolating new compounds. We are interested in projects directed at assessing microbial diversity using both culture independent and culture dependent methods. As is evident from the Field Work tab on this web page, we have on-going collection programs in Canada’s Arctic, Colombia, the Mediterranean, the Black Sea, The Bahamas as well as Atlantic Canada. |
Accessing Cryptic Natural Product Biosynthetic Pathways
 |
Through funding from NSERC, we have a number of student and postdoc projects that seek to develop new methods for the isolation of marine-derived microbes thus allowing access to new sources of natural products. Further, this research program aims to develop new methods to induce natural product production in microbial fermentation and seeks to develop a new chemical tool to efficiently identify new natural products from large sets of complex mixtures. Lastly, antimicrobial assays of relevance to veterinary medicine will be used to guide the isolation and characterization of new natural products. Overall, this research program will develop research methods that will enhance the rate of discovery of new bioactive natural products. |
 |
Marine Microbes as a New Source of Ingredients for the Personal Care Industry

Identification of novel enzymes involved in the breakdown of plant fibre to be used in the development of a ruminant feed additive
In collaboration with Nautilus and AB Vista, we are screening our marine microbial library for enzymes with applications as a feed additive for the ruminant feed industry which can increase fibre digestion. The overall goal of this project is to identify new novel xylanase, cellulase and endoglucanase activities and accessory enzymes (arabinofuranosidase, xylosidase and glucuronidases) which can be used to develop a new ruminant feed additive which will increase feed efficiency and productivity.